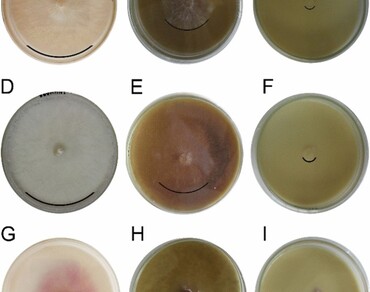
Antifungal activity of Mosiera bullata (Britton & P. Wilson) extract against phytopathogenic fungi

Vol 36 Issue 4, December 2023
Total Articles: 47

Some functional properties, antioxidant and bactericidal activities of Garcinia kola Heckel protein hydrolysates: in vitro
Research Articles
Views: 4186
Pages: 1231-1238
Published: 06 December, 2022
Doi: 10.1007/s42535-022-00526-9

Trees of the Trans-Himalaya: first report of Pinus wallichiana A. B. Jackson from Ladakh
Research Articles
Views: 4416
Pages: 1239-1244
Published: 04 November, 2022
Doi: 10.1007/s42535-022-00497-x

Biosynthesis of silver nanoparticles using the endophyte Enterobacter roggenkampii BLS02 from Barleria lupulina and their role in the inhibition of food borne bacteria
Research Articles
Views: 3916
Pages: 1245-1255
Published: 16 November, 2022
Doi: 10.1007/s42535-022-00514-z

New distributional records of lichenized fungi for India from Assam
Research Articles
Views: 4255
Pages: 1256-1264
Published: 02 December, 2022
Doi: 10.1007/s42535-022-00523-y

Transgenic lettuce (Lactuca sativa L.) harboring chitinase gene expressed resistance against a devastating fungus, Sclerotinia sclerotiorum
Research Articles
Views: 4079
Pages: 1265-1274
Published: 19 November, 2022
Doi: 10.1007/s42535-022-00519-8

Sustainable livelihoods study and salt tolerance effects on two important arid region tree species Prosopis cineraria (L.) Druze and Prosopis juliflora (Sw.) DC
Research Articles
Views: 4212
Pages: 1275-1284
Published: 06 December, 2022
Doi: 10.1007/s42535-022-00528-7

Anti-oxidant, anti-proliferative activities and characterization of secondary metabolites using Q-TOF-LC-MS/MS analysis of anti-aging medicinal plant Holostemma ada-kodien
Research Articles
Views: 3903
Pages: 1285-1294
Published: 07 December, 2022
Doi: 10.1007/s42535-022-00529-6
Antifungal activity of Mosiera bullata (Britton & P. Wilson) extract against phytopathogenic fungi
Research Articles
Views: 2247
Pages: 1295-1304
Published: 19 December, 2022
Doi: 10.1007/s42535-022-00540-x

Micropropagation of an ethnomedicinal plant Solanum torvum Swartz
Research Articles
Views: 3973
Pages: 1305-1312
Published: 06 December, 2022
Doi: 10.1007/s42535-022-00502-3